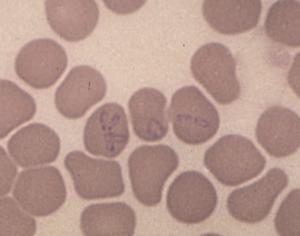

The following as well as the other links to the Medscape site have expired as of Jan 2004
http://www.medscape.com/Medscape/CNO/1999/lyme/PrintDay.cfm?conference_id=21&day_num=1

Conference Summaries
12th International Conference on Lyme Disease and Other Spirochetal and Tick-Borne Disorders
Day 1 - April 9, 1999
(Valid for CME until October 10, 1999)
Day 2 - April 10, 1999
If you cannot register online and complete the course, you may also receive credit by mailing your completed Registration form, Post Test and Evaluation Forms to:
 |
Medical Education Collaborative
1800 Jackson Street, Suite 200
Golden, CO 80401
Telephone: (303) 278-1900
|
Learning Objectives
These daily summaries from the 12th International Conference on Lyme
Disease and Other Spirochetal and Tick-Borne Disorders are intended for
frontline infectious diseases, internal medicine, family practice,
pediatric, other primary care physicians, and pharmacists who are likely to treat
patients with Lyme disease.
Upon completion of this self-study course, participants will be able to:
| 1. |
Explain Lyme disease pathogenesis. |
| 2. |
Describe the presentation and treatment of neurologic Lyme disease. |
| 3. |
Describe the status and complexities of Lyme disease vaccine development. |
Table of Contents
* In order to receive CME credit, please remember to register, read all CME topics for this day and submit the Post Test and Evaluation.
Today's Summaries
Keynote Address - The Complexity of Vector-borne Spirochetes (Borrelia spp)
The keynote speaker at this conference was Willy Burgdorfer, PhD, of the National Institutes of Health. In the late 1970s, Dr. Burgdorfer and I began debating whether the lone star tick, Amblyomma americanum, transmits pathogenic spotted fever group rickettsia to humans. In 1981, Dr. Burgdorfer was looking for rickettsia in New York ticks when he detected spirochetes -- the organisms, subsequently named Borrelia burgdorferi, that we now know to be the etiologic agents of Lyme disease. In his lecture, Dr. Burgdorfer reviewed the scientific literature past (much of it no longer written in English) and present, dealing with spirochetal cysts, blebs, and spherules.
Because of the seminal nature of his work, Dr. Burgdorfer's presentation is posted here in its entirety. As you read his review of work in this area to date, keep in mind much remains to be done. It is possible that spirochetal bleb formation signals the organism's impending death. The research reviewed here, however, suggests that it is a survival mechanism, which of course, has implications regarding patient management.
-- Julie Rawlings, MPH
The Complexity of Arthropod-borne Spirochetes (Borrelia spp)
Speaker: Willy Burgdorfer, PhD

Today's investigators, eager to apply their sophisticated microscopic, immunochemical, molecular and genetic methodologies often are not aware that their research objectives are similar if not identical to those of earlier workers whose publications unfortunately may no longer be available or are published in foreign journals.
My talk today identifies the highly controversial historical findings related to the biology and vector(s)/host relationships of borreliae, and emphasizes their importance to our current investigations of Lyme disease and its spirochetes. Let us briefly recall that the first discovery of spriochetes pathogenic to humans is credited to the German physician Dr. Otto Obermeier (Fig. 1) who as early as 1868 during an epidemic in Berlin detected in the blood of relapsing fever patients highly motile threadlike microorganisms (Fig. 2) that in morphology were similar to the water spirochetes Spirocheta plicatilis -- a spirochete detected in 1835 by Dr. Ehrenberg.

Figure 1

Figure 2
In 1878, the physician Gregor Münch was the first to express the idea that recurrent or relapsing fever may be transmitted by the bite of blood-sucking arthropods such as lice, fleas and bugs. The theory of lice being the vector was confirmed later by the French microbiologists Sergent and Foley in 1910.
At the turn of the century, 1903 through 1905, the British physicians Dutton (Joseph Everett) and Todd (John Lancelot) working in the Congo, and independently Ross (Philip Hedorland) and Milne (Arthur Dawson) active in Uganda, found that the disease referred to as "human tick disease" by Livingston (David) as early as 1857, was caused by a spirochete transmitted by the African soft-shelled or argasid tick, Orhithodoros moubata (Fig. 3). Both Dutton and Todd contracted the disease. Dutton, a pathologist, infected himself accidentally during a post mortem and died. He is remembered by having had named the East African relapsing fever spirochete Borrelia duttonii.

Figure 3
Also playing an important role in relapsing fever research was the German microbiologist Robert Koch. At the end of 1904, he was called to East Africa to investigate the widely distributed East Coast Fever in cattle. He soon learned that most Europeans traveling into the interior regions had been suffering of recurrent fever first thought to be malaria. Although Koch was not aware of the British findings in the Congo and Uganda, he confirmed the vector role of the Ornithodoros moubata. He was the first to demonstrate that spirochetes were transmitted via eggs (transovarial transmission) to the progeny of infected female ticks.
Ever since it was demonstrated that the body louse (Pediculus humanus humanus) and the African O moubata were the vectors of the relapsing fever spirochetes known today as Borrelia recurrentis and B duttonii, respectively, intense studies have been carried out on the development of these microorganisms in their vectors, and on the mode of transmission to humans. Thus, in 1912, the French worker Charles Nicolle and coworkers studied the behavior of B recurrentis in lice and noted that the spirochetes had disappeared from the midgut 24 hours after they had been ingested; they were no longer detectable until days 6 to 8 when they suddenly reappeared in the hemolymph.
A similar "negative phase" had previously been reported for B duttonii in O moubata by Dutton and Todd (1905-1907), Leishman and other investigators (1907-1920), Fantham (1911-1915), Hindle (1911), and later also by Hatt (1929) and Nicolle and associates (1930). According to these investigators, ingested spirochetes invade the gut epithelium where they lose motility and after 3 to 4 days develop into cysts (blebs, vesicles) that contain granules or chromatin bodies (Fig. 4). Duton and Todd postulated that these spherules are formed by protuberance of the spirochetes periplasmic membranes; they may occur at any point along the spirochete. At some time during their development, these spherules or cysts were said to burst and release their granules. By the 10th day after infectious feeding, Dutton and Todd no longer found morphologically typical spirochetes, but instead large numbers of granules from which eventually new spirochetes developed provided the ticks were maintained at temperatures above 25° C.

Figure 4
Hindle, in 1911, reported similar observations. In infected ticks held at 21° C, the spirochetes had disappeared from the midgut by the 10th day after infectious feeding. They could no longer be detected either in the gut or in the tissues. However, triturates of such ticks injected into mice regularly proved infective, and an increase in temperature to 35° C resulted in the reappearance of morphologically typical spirochetes.
This "granulation theory" -- as it was referred to -- received a significant boost in 1950 when Edward Hampp of the National Institute of Dental Research in Bethesda showed by stained smears, darkfield and electron microscopy that oral treponemes and Borrelia vincenti in cultures produce blebs and granules that were considered "germinative units." His hypothesis was supported by the observation that 31 month-old cultures containing only granules invariably resulted in typical spirochetes upon transfer to fresh medium.
Similar observations were also reported by DeLamater and coworkers from the University of Pennsylvania Medical School. They provided evidence for the occurrence of a complex life cycle in the pathogenic and nonpathogenic strains of Treponema pallidum. Accordingly, these spirochetes multiply by (1) transverse or binary fission, and (2) by producing gemmae (cysts in which a single or more granules appeared to be the primordia of daughter spirochetes).
In contrast, there were many investigators, including Wittrock (1913), Kleine and Eckard (1913), Kleine and Krause (1932), Feng and Chung (1936-39), and your speaker (Burgdorfer, 1951), who conducted dynamic investigations on the development of various species of borreliae in lice or ticks and found no evidence of a negative phase or complex life cycle.
It is now generally accepted that B recurrentis spirochetes in the body louse, P humanus humanus, following ingestion with a patient's blood, arrive in the midgut where most are destined to die (Fig. 5). Those that survive, within a few hours after ingestion pass through the gut wall into the hemolymph where they undergo massive multiplication by binary fission. As a result, large concentrations of spirochetes are found in the hemolymph surrounding the various tissues as early as 8 to 10 days after ingestion.

Figure 5
Similarly, O moubata and other relapsing fever ticks, during their short feeding (10 to 30 minutes), ingest spirochetes into the midgut where they can be demonstrated in gradually decreasing numbers for about 14 days but not longer (Fig. 6). Within hours after the ticks had engorged, spirochetes accumulate in the intercellular spaces of the gut epithelium (Fig. 7) from where as early as 24 hours after ingestion, they penetrate the basement membrane to enter the body cavity where they undergo massive multiplication by binary fission (Figs. 8, 9).

Figure 6

Figure 7

Figure 8

Figure 9
Although most of the above mentioned opponents of the "granulation theory" verified the formation and existence of cysts, blebs, spherules associated with spirochetes, they considered them as degeneration products.
Thus the question of "negative phase" and "complex developmental cycle" appeared to be settled until in 1981 your speaker discovered the Lyme disease spirochete -- now known as Borrelia burgdorferi -- associated with ticks of the Ixodes ricinus/persulcatus complex (Fig. 10). This relatively large Borrelia is not readily detectable in blood smears or thick drops of Lyme disease patients and susceptible host animals, yet engorgement on infected hosts results in up to 100% infected ticks.

Figure 10
Unlike the other louse and tick-borne borreliae that leave the midgut of their vectors shortly after ingestion to cause a hemolymph-limited or systemic infection, B burgdorferi in most of its tick vectors remains in the midgut where it aggregates near the microvillar brushborder and in the intercellular spaces of the gut epithelium. From there, it may penetrate the gut wall during and after engorgement and may initiate a systemic infection particularly in the tissues of the ticks' central ganglion, ovary and Malpighian tubules. Regardless of such generalized infections, however, the midgut remains infected throughout the life span of the tick.
Of particular interest to our discussion is the presence in freshly engorged Lyme disease ticks of spirochetes with outer membrane-associated cysts, blebs or spherules that often contain numerous granules with surrounding trilaminar membranes (Figs. 11,12). Because the internal material of these granules is similar in appearance and electron density to that of typical spirochetes and because these cysts (blebs, spherules) strongly react when treated with FITC-labeled conjugates, the questions concerning a complex life cycle of borreliae have again been raised and induced investigators to critically examine the nature and function of these formations -- a research problem referred to for the first time almost 100 years ago by Dutton and Todd.

Figure 11

Figure 12
Thus, RML scientists Dave Dorward and Claude Gron using silver staining, transmission and scanning electron microscopy investigated the nature of naturally elaborated membrane blebs on the surface of cultured B burgdorferi or free in the medium, and found both linear and circular DNA (Fig. 13). The fact that his material was packaged within the membrane-derived vesicles suggested that it might play a role in the protection of genetic markers. In vivo and in vitro exposure of B burgdorferi to antibiotics (penicillin G, ceftriaxon) were shown by Preac-Mursic and associates to produce cytomorphic atypical but motile spirochetes with numerous membrane-derived vesicles (spheroblast -- L-forms) (Fig. 14).[1]

Figure 13

Figure 14
In their recent publication, Brorson and Brorson reported on the "In vitro Conversion of Borrellia burgdorferi to Cystic Forms in Spinal Fluid, and on the Transformation to Mobile Spirochetes by Incubation in BSK-H Medium."[2] Accordingly, B burgdorferi converted rapidly to cystic forms when transferred to spinal fluid. No normal spirochetes were left after 24 hours of incubation at 37° C; all were converted to cysts. When these cystic forms were transferred to a rich (BSK-H) medium, the cysts were converted back to normal, mobile spirochetes after incubation for 9 to 17 days.
These most recent findings do confirm the development of membrane-derived cysts, blebs, spherules, vesicles and the potential transformation to motile, helical spirochetes, not as part of a complex developmental cycle -- as postulated by Dutton and associates -- but rather as a "survival mechanism" of spirochetes to overcome or escape unfavorable conditions. Such conditions prevail during early phases of infection when spirochetes ingested into the midgut of ticks or lice become exposed to the vectors' digestive enzymes and tissue barriers (peritrophic membrane, gut epithelium). As a result, most detectable spirochetes produce numerous cysts often filled with granular material.
Other in vitro and in vivo factors shown to induce development of cysts include unsatisfactory culturing conditions, presence of antibodies and the effects of antibiotics.
Using silver impregnations and immunochemical staining, cystic material has been demonstrated in every animal and human tissue infected by B burgdorferi. As yet, it is not known whether these forms of Borrelia represent products of degenerated spirochetes or of surviving organisms capable of transforming to typical spirochetes once the faborable environmental conditions are restored. It is tempting to speculate, however, that the survival mechanism of spirochetes is responsible for the diverse pathology of these organisms as well as for their ability to survive as cystic forms thereby producing prolonged, chronic and periodically recurrent disease.
References
- Preac-Mursic V, Wanner G, Reinhardt S, et al: Formation and Cultivation of Borrelia burgdorferi Spheroplast-L-Form Variants. Infection 24(3):218-225, 1996.
- Brornson O, Brornson SH: In Vitro Conversion of Borrelia burgdorferi to Cystic Forms in Spinal Fluid, and Transformation to Motile Spirochetes by Incubation in BSK-H Medium. Infection 26(30):218-225, 1996.Infection 26(3):144-150, 1998.
Neurologic Lyme Disease
Brian A. Fallon, MD
Lyme disease, caused by the tick-borne pathogen, Borrelia burgdorferi (Bb), is the major human spirochetal infection in the United States and Europe. Neurologic involvement occurs in up to 40% of symptomatic infections. Two presentations today outlined some of the complexities of this illness and described new tools to assist in diagnosing cases of central nervous system (CNS) Lyme Disease.
Dr. Patricia Coyle, of the State University of New York at Stony Brook, described the typical neurologic presentations in Lyme disease, as well as some of the atypical ones.[1] Lyme disease may be categorized into three stages: early localized infection, early disseminated infection, and late disseminated infection. Early localized infection is characterized by the erythema migrans (EM) rash, although in some cases the infection is no longer localized as a result of CNS seeding that may occur even before the EM rash appears. Early disseminated infection may result in meningitis, cranial nerve palsy, or acute radiculoneuritis.
Late disseminated infection may result in encephalopathy (the most common manifestation of chronic neurologic Lyme disease), encephalomyelitis (which at times may appear similar to multiple sclerosis but most often without the cerebrospinal fluid production of oligoclonal bands), and polyradiculoneuropathy. The pathology of CNS Lyme disease is most notable for a lack of tissue destruction, signifying that the pathophysiology has less to do with direct damage and more to do with a provoked immune or inflammatory response. Immunomodulatory therapies, therefore, may have a role in the treatment of neurologic Lyme disease. Steroid treatment, however, should be avoided as it may exacerbate the illness.
Why CNS Lyme Disease is Poorly Understood
The gaps in our understanding of CNS Lyme disease stem from several factors. First, we lack a definitive assay to demonstrate active infection. Second, Bb infection can be occult, resulting in long periods of latency before symptoms are manifest. Third, Bb can disseminate to sequestered compartments where antibiotic penetration is difficult and immune surveillance is lacking. Fourth, Bb is known to have considerable strain heterogeneity. This strain heterogeneity may result in different levels of virulence and different organotropism. For example, some strains may be more likely to result in arthritic or skin disease whereas others may target the nervous system.
Fifth, the antigenic variability of Bb is known to result in different antigen expression in different locales. In the tick, outer surface protein (Osp) A is expressed, whereas in the human it is upregulated to Osp C (prior to transfer to the host by the tick). However, Osp A may be preferentially expressed in the CSF compartment, as the studies at Stony Brook have demonstrated. CSF studies at Stony Brook also have demonstrated a strong immunoglobulin M response, the presence of immune complexes, and a prominent TH1 proinflammatory cytokine response. Sixth, the significance of coinfection with other tick-borne organisms such as Babesia is not fully understood. Such co-infection may be misdiagnosed as being only Lyme disease and result in more severe and refractory cases of Lyme disease.
Finally, although there are well-characterized neurologic syndromes associated with early and late stage infection, the full spectrum of neurologic Lyme Disease has not yet been fully described. Patients with new onset Bb infection may develop an acute CNS demyelinated disease that looks much like multiple sclerosis; although rare, these cases do occur and do respond well to intravenous antibiotic therapy. Stroke-like syndromes and CNS vasculitis have also been induced by CNS infection with Bb.
The optimal treatment of neurologic Lyme disease is not yet known. Intravenous antibiotic therapy with Ceftriaxone or Cefotaxime is the accepted standard because these drugs more effectively penetrate the blood-brain-barrier. In studies of Lyme arthritis in which patients were treated with oral antibiotics, the treatment failures often showed signs of neurologic involvement, suggesting that oral antibiotics may be insufficient to eradicate infection that may already be sequestered in the CNS compartment.
Dr. Coyle presented preliminary results from a study of children and adults being conducted at the University Hospital at Stony Brook. Of the adult patients, the sample was primarily early Lyme disease: 40% had EM; 22% had a Bell's Palsy; and 17% had multifocal EM. Of this sample of 18 adults, although 47% had evidence of Bb antibody in the CSF, only 12% had evidence of intrathecal antibody production. In the 12 children with early-disseminated Lyme disease, 67% had a facial nerve palsy and 25% had multiple EM; of these, only 17% had evidence of intrathecal antibody production.
These findings were reinforced by earlier work done by the SUNY group in collaboration with Dr. Steven Schutzer and others in which immune complex dissociation enabled the disentangling of immune complexes and therefore the detection of Osp antigen and Bb antibodies.[2,3] Dr. Coyle emphasized that, unlike European Lyme disease, North American neurologic Lyme disease does not commonly demonstrate intrathecal antibody production. Therefore, the absence of intrathecal antibody production cannot rule out the presence of active neurologic Lyme disease, as in most cases such intrathecal production does not occur. The most common symptoms in the adults were fatigue, stiff neck, headache, and cognitive problems, whereas the most common symptoms in the children were headaches, sleep problems, fatigue and mood disturbances -- but not memory problems. Dr. Coyle concluded by noting that adults with neurologic Lyme disease appear to be more symptomatic than children.
New Diagnostic Tools Needed
Dr. Ronald Van Heertum, of the Columbia University College of Physicians and Surgeons, addressed the role of functional brain imaging in the diagnosis of chronic CNS Lyme disease.[4] The need for such adjunctive diagnostic tools stems from the often nonspecific neurobehavioral symptoms presented by patients with chronic Lyme disease.
CT and MRI scans often may not reveal abnormalities in these patients. But functional brain imaging, particularly SPECT imaging, shows promise as a contributory adjunctive diagnostic technique, based on the assumption that brain blood and metabolism are tightly coupled.[5] The most up-to-date SPECT scans use a triple-headed machine, but Dr. Van Heertum suggested that dual-headed machines also may produce useful images.
In about 70% of chronic Lyme disease patients with cogntive symptoms, brain SPECT scans typically reveal a pattern of global hypoperfusion in a heterogeneous distribution through the white matter.[6] This pattern is not specific for Lyme disease; it can also be seen in other CNS syndromes such as HIV encephalopathy, viral encephalopathy, chronic cocaine use, and vasculitides. However, this pattern is different from what one would see with normal controls, patients with primary depression, patients with Alzheimer's disease, and patients with focal brain damage as in stroke.
Dr. Van Heertum presented a recent study from Columbia University, conducted with Drs. Lestor Johnson and Vitale Furman, of 20 patients with chronic Lyme disease and 7 normal controls whose brain SPECT scans were subjected to an SPM analysis. This quantitative approach to the evaluation of a SPECT image allows comparison of the blood flow in small areas or pixels of brain. Remarkably, the Lyme patients as a group (and each Lyme patient individually) had significantly reduced uptake of radioactive tracer (perfusion), primarily in the white matter. These results suggest that the primary pathology in Lyme disease is related to white matter dysfunction.
In conclusion, Dr. Van Heertum emphasized that SPECT imaging can have a role in Lyme disease by helping to demonstrate diffuse CNS involvement, differentiating Lyme disease from other syndromes that do not cause a diffuse process, and in monitoring the course of treatment.
References
- Coyle PK: Neurologic Lyme disease update. 12th International Conference on Lyme Disease and Other Spirochetal and Tick-Borne Disorders, New York, NY, 1999.
- Coyle PK, Schutzer SE, Deng Z, et al: Detection of Bb-specific antigen in antibody-negative cerebrospinal fluid in neurologic Lyme disease. Neurology 45:2010-2015, 1995.
- Coyle PK, Deng Z, ,Schutzer SE, et al: Detection of Bb antigens in cerebrospinal fluid. Neurology 43:1093-97, 1993.
- Heertum RV: Functional brain imaging in the diagnosis of chronic CNS Lyme disaese. 12th International Conference on Lyme Disease and Other Spirochetal and Tick-Borne Disorders, New York, NY, 1999.
- Logigian EL, Johnson KA, Kijewski MF, et al: Reversible cerebral hypoperfusion in Lyme encephalopathy. Neurology 49:1661-1670, 1997.
- Fallon BA, Das S, Plutchok JJ, et al: Functional brain imaging and neuropsychological testing in Lyme Disease. Clin Infectious Disease 25(s):57-63, 1997.
OspA Induces Lyme Arthritis in Hamsters
Charles S. Pavia, PhD
During the second half of the session that dealt with vaccines, Dr. Ronald Schell, of the University of Wisconsin School of Medicine in Madison, gave a presentation on the possible association between the use of a Lyme disease vaccine -- such as those already commercially available or which have recently been made available for human use -- and the induction of arthritis.[1] Dr. Schell is a recognized expert on microbiologic and immune aspects related to spirochetal infections and diseases.
Dr. Schell pointed out that arthritis is a frequent complication in patients who fail to receive early treatment for Borrelia burgdorferi infection and thus they would be suitable candidates for vaccine intervention. To better understand the events associated with Lyme arthritis, Dr. Schell and his research group have developed an infectious animal model using the hamster. Dr. Schell says the hamster model closely mimics some of the Lyme disease processes seen in humans, and he believes it is quite suitable for evaluating the safety and efficacy of candidate vaccines.
A Newly FDA-Approved Lyme Vaccine Exists, Yet...
Despite impressive progress that was made in Phase 1 to 3 clinical trials with this recently approved vaccine, Dr. Schell cautioned that in studies in his lab, severe destructive arthritis (SDA) developed in vaccinated hamsters after they were administered a challenge infection with live B burgdorferi. Dr. Schell says he used the same type of approved vaccine which consists of recombinant-derived outer surface protein (Osp) A.
Dr. Schell told attendees that several studies laid the groundwork for these most recent findings. More specifically, those earlier studies demonstrated that inactivated, whole borrelial organisms, when used as a vaccine, do not protect hamsters from developing SDA. SDA, in this animal model, is manifested by swelling and pathologic changes in the hind footpads lasting for several days to weeks. These changes occurred most often 14 to 16 days after challenge in previously vaccinated animals. The severity and duration of SDA depended upon the size of the challenge. For example, exposure to more than 1 million bacteria made the hamsters seriously ill, Dr. Schell said. However, it is noteworthy, he added, that challenging the hamsters during the 5th week following vaccination, and up to the 26th week following vaccination, did not lead to SDA or any detectable histopathologic changes. Vaccinated hamsters challenged 26 or 52 weeks later did develop SDA. In addition to the infectious vaccine-derived isolate, various other strains of B burgdorferi were capable of causing SDA.
These results raise some concerns about fully implementing a problem-free, human vaccination program, Dr. Schell said, even though his findings were obtained with a whole cell vaccine. Therefore, use of a less complex, subunit vaccine would seem to be a more logical choice in considering efforts to avoid adverse effects.
To investigate this issue. Schell and his group vaccinated the hamsters with 30 ug of OspA (30 ug is the current, recommended amount given to people), and then challenged the animals with 1 million Borrelia bacteria. Swelling was detected 5 days after challenge and increased rapidly, with peak swelling occurring on day 11, followed by gradually decreased swelling. Matched vaccinated controls that were inoculated with Barbour-Stoenner-Kelly (BSK) culture medium did not develop any swelling or other complications. Similar results occurred in challenged hamsters pre-immunized with higher concentrations of OspA (60 or 100 ug) or with a commercially available recombinant OspA designed for veterinary use (ie, primarily for dogs).
Some of these vaccine preparations contain an adjuvant(s) designed to boost the immune system with the intent of increasing the amount of antibodies being produced. Dr. Schell points out, however, that these adjuvants could contribute to some of the damaging side effects seen in his experiments, such as the SDA occurring in his hamsters.
In further related studies, Dr. Schell showed that SDA was readily induced in the vaccinated and challenged hamsters before borreliacidal antibodies developed and after a protective borreliacidal response began to decline.
Conclusions
Dr. Schell concluded his presentation by stressing the need for other vaccine formulations to be considered, perhaps formulations that might prove safer and easier to administer while maintaining acceptable efficacy. Among such alternate formulations are vaccines that employ various combinations of B burgdorferi proteins. These combinations could include a mixture of several different recombinant proteins or of whole inactivated/attenuated organisms. Dr. Schell says he hopes that such preparations will prove capable of inducing broad cross-protection against diverse strains of B burgdorferi, while removing or excluding those components capable of causing autoreactive pathologic responses.
Some attendees at the conference voiced reservations they had with Dr. Schell's findings. These included:
- Dr. Schell's work involved using only culture-grown organisms as the source of the challenge inoculum rather than including direct challenge with Borrelia-infected ticks, as would naturally occur in humans. Such differences in challenge, they said, could seriously influence test results on the induction of SDA.
- Is the hamster truly a suitable model for human Lyme disease? If not, then, some of the results reported by Dr. Schell may not apply directly to humans. This might relate especially to the site used for depositing the infectious challenge inoculum; the hamster's hind footpad, which is where swelling and SDA developed. Perhaps, part of this response by the challenged hamsters may be a variation of an expected (albeit, exaggerated) delayed-type hypersensitivity reaction.
Reference
- Schell RF: OspA induces Lyme arthritis in Hamsters. 12th International Conference on Lyme Disease and Other Tick-Borne Disorders, New York, NY, 1999.
Suggested Readings
- DuChateau BK, Munson EL; Schell RF: Macrophages interact with enriched populations of distinct T-lymphocyte subsets for the induction of severe destructive Lyme arthritis. J Leukocyte Biol 65:162-70, 1999.
- Padilla ML, Callister SM, Schell RF, et al: Characterization of the protective borreliacidal antibody response in humans and hamsters after vaccination with B. burgdorferi outer surface protein A. J Infect Dis 174:739, 1996
- Lim LCL, England DM, Ö Schell RF: Development of destructive arthritis in vaccinated hamsters challenged with Borrelia burgdorferi. Infect Immun 62:2825, 1994.
- Wormser GP: Vaccination as a modality to prevent Lyme disease. A status report. Infect Dis Clin North America 13:135-148.
- Foley DM, Blanco DR, Lovett MA, et al: Limitations of the OspA vaccine for humans; A review. J Spirochetal Tick-Borne Dis 5:69-74.
Histopathology of Human Lyme Disease: An Update
Paul M. Duray, MD
Tracing the pathophysiologic picture of non-relapsing fever Borrelia (Fig. 1) is challenging because tissue biopsies are uncommon in medical practice and the disorder isn't expected to be lethal. Thus, there are wide gaps in our knowledge of the histopathology of Lyme disease.[1] However, archived cases accumulated at referral centers, particularly in endemic regions, have added valuable information to our understanding of acute onset and long-term effects of the disease.

Figure 1
Characteristics of Primary and Long-term Infection
With some exceptions, inflammatory cell responses consist of lymphocytes in variable maturation, plasma cells, macrophages and mast cells. The acute, primary lesion is dermatologic erythema migrans with simple lymphoplasmacellular cuffs around dermal vessels (Fig. 2). With very rare exception, the perivascular infiltrates are confined to the upper reticular dermis, sparing the lower dermis, a helpful clue that the dermatitis belongs to the category of erythematous disorders.

Figure 2
When examined by silver impregnation stain, this non-specific but suggestible infiltrate may be accompanied by spirochetes in the collagen. Rarely, the dermatitis may involve deeper vessels, even in the sub-dermal fat, which may resemble lupus erythematosus. Long-term infections have additional microvascular changes including angiopathy -- primarily occlusive changes similar to the post-capillary venulitis seen in syphilis.
Patients in Europe have been seen with a lesion of skin referred to as Borrelia lymphocytoma or lymphadenosis benigna cutis, usually involving the ear lobe, lateral neck skin, or areola of the nipple. The histology is instantly recognizable by a marked dermal infiltrate of lymphocytes and other mononuclear inflammatory cells totally, or nearly totally replacing the dermis, with well-formed germinal centers (Fig. 3), as seen in lymph nodes or tonsillar lymphoid tissue, hence the term lymphadenosis. This is a remarkable lesion clinically and pathologically and is not always caused by Borrelia infection. When it is, however, the clinician should look for the spirochetes, which can be seen by silver stains. Other examples of early disseminated infection, which may be seen days to weeks following tick bite, include meningitis, radiculoneuritis, encephalopathy and Bell's palsy.

Figure 3
In these tissues, the lymphoplasmacellular response again is perivascular. But in the autonomic ganglia, the inflammatory lymphoid infiltrate additionally is associated with apparent ganglion cell loss (Fig. 4). The lymphocytes also are linear within the longitudinal nerves and can be seen associated with vasculature in the nerve (endoneural), as well as outside the nerve (perineural). Borrelial carditis, characterized by variable AV block, is associated with both endocarditis and transmural ventricular interstitial lymphocytes, plasma cells, and macrophages (Fig. 5). Rarely the infiltrates may induce pericardial effusion.

Figure 4

Figure 5
Joint Complications
In later stages, joint synovitis, if severe and/or repetitive, may lead to bone erosion (true arthritis). Synovial pathology is variable and some cases are virtually indistinguishable from active rheumatoid arthritis. Lyme synovitis/arthritis is highly correlated with the presence of marked deposition of fibrin in a diffuse distribution beneath the synovial membrane. This is usually seen in association with a degenerative, inflamed pseudo-membrane on the surface of synovial membranes.
Another pattern seen in Lyme arthritis/synovitis is hypertrophic villous synovitis, a non-specific histologic lesion seen in other oligoarthritides, including undifferentiated arthritis. Here, the synovial surface is folded into fronds, yielding a villous appearance. Synovial surface cells are either of normal thickness or can thicken to 5-6 cells. The stroma of the villi demonstrate vascular proliferation (angiogenesis) to a degree that simulates a capillary hemangioma. Plasma cells are found in abundance in Lyme synovitis and are associated with large numbers of Giemsa stain-positive tissue mast cells.
Remaining Histopathologic Questions
Our knowledge of the CNS changes that occur in Lyme disease is incomplete, especially with regard to the clinical states of cerebral symptoms and dysfunction, and meningoencephalitis-type clinical pictures. Extremely limited tissue samples, however, have indicated the presence of perivascular mononuclear cells in the cerebral cortex and sporadic aggregates of microglial cells. The vessels in cortical grey matter may or may not have occlusive lumens, also called occlusive microangiopathy, a form of low-grade small vessel vasculitis, but without the intravascular and perivascular nuclear karryorhexis debris that characterizes the vasculitis of leucocytoclastic vasculitis.
Late disseminated infection of the skin is called acrodermatitis chronica atrophicans and occurs mainly in Europe. Histopathology in these cases is characterized by transdermal, comparatively dense and diffuse mononuclear inflammatory cells, including plasma cells, in association with dilated lymphatics (Fig. 6). The degree of these findings varies from case to case, but dermal inflammation is significantly greater than that of erythema migrans. Spirochetes can be demonstrated in many of these pathologic lesions except recurrent synovitis, which may be a molecular cross-reactive phenomenon. Spirochetes are always difficult to demonstrate in patients who have had prior or concurrent antibiotic therapy.

Figure 6
The spectrum of histopathologic lesions in human Lyme borreliosis also is poorly understood in tissues such as urinary bladder and gastrointestinal tract, both sites that could be involved in human infection. Additional experience will help us to fill these and other remaining gaps in our knowledge of this disease.
Reference
- Duray P: Update on tick-associated human histopathology. 12th International Conference on Lyme Disease and Other Spirochetal and Tick-Borne Disorders, New York, NY, 1999.
Ehrlichiosis, Babesiosis and Lyme Disease
Julie Rawlings, MPH
Dr. Ed Masters, a family practice physician from Cape Girardeau, Mo., who has spent years following the incidence of Lyme disease in his state, reports seeing 20-40 patients per year with acute illness.[1] Such numbers are substantial, especially considering that Missouri has not been an area of the US considered to be highly endemic for the illness. It is estimated that 1-2% of Missouri's lone star ticks harbor spirochetes. Interestingly, a recent telephone survey indicating that 24% of Missouri residents questioned reported they had had a tick bite in the preceding 30 days.
The patients that Dr. Masters sees often present with erythema migrans lesions (Figs. 1-3) that are very similar to those seen in the northeastern US, an area that is highly endemic for Lyme disease, and in Europe. Many patients have sequelae, including Bell's palsy, third nerve palsies, and arthritis.

Figure 1

Figure 2

Figure 3
Ixodes scapularis, the black-legged tick, is the vector of Lyme disease, human granulocytic ehrlichiosis (HGE) caused by an Ehrlichia phagocytophylia-like organism, and Babesia agents in the northeastern United States. This tick species can be found in Missouri, although it bites humans relatively infrequently. Epidemiologic and laboratory data suggest that Amblyomma americanum, the lone star tick (Fig. 4), is the primary vector of tick-borne diseases in Missouri. This species, very common in the south-central US, readily feed on humans. The adults are about the size of a watermelon seed; the adult female is distinguished by a white dot on the middle of her back.

Figure 4
Table: Tick-borne Organisms Transmitted by Ixodes scapularis and Ambloymma americanum
| Tick Species |
Ixodes scapularis |
Amblyomma americanum |
|---|
| Geographic Area |
Northeast, north-central US |
South, midwest US |
| Babesia species |
Babesia microti |
Missouri Babesia MO1 |
| Ehrlichia species |
Ehrlichia phagoctyophylla-like organism |
Ehrlichia chaffeensis |
| Borrelia species |
Borrelia burgdorferi |
Borrelia sp |
Cases of human monocytotropic ehrlichiosis (HME) due to Ehrlichia chaffeensis (Fig. 5), babesiosis due to a distinct intraerythrocytic piroplasm that appears to be related to B divergens (Fig. 6), and Rocky Mountain spotted fever due to Rickettsia ricketsii, have also been diagnosed in southeast Missouri.

Figure 5
Figure 6
Dr. Masters is collaborating with Dr. David Walker et al, at the University of Texas Medical Branch in Galveston on an HME study. Now that they are looking for it, 22 ehrlichiosis cases have been confirmed in the last two years; only one or two cases per year had been reported in previous years. At least two of the ehrlichiosis patients also had Lyme disease.
Dr. Masters reminded clinicians that a diagnosis of ehrlichiosis should be considered when patients present with a febrile illness accompanied by decreased platelets and white blood cells and elevated liver function tests following tick exposure. The lone star tick is the vector of ehrlichiosis.
No vector studies have been conducted using the Missouri Babesia, called MO 1. However, Dr. Masters concluded his presentation by postulating that, in addition to its involvement in the transmission of the more common tick-borne organisms, the lone star tick may transmit this parasite. Dr. Masters wondered whether, because of evolutionary divergence, there is a tick-vectored clinical triad of Lyme disease, babesiosis and ehrlichiosis in the north associated with I scapularis and another in the south associated with A americanum.
During the question and answer session following his talk, Dr. Masters was asked whether he prophylactically treats tick bites. He noted that since only a small percentage of Missouri ticks were infected with spirochetes, prophylaxis really did not make sense.
Reference
- Masters EJ: Ehrlichiosis, Babesiosis, and Borreliosis. 12th International Conference on Lyme Disease and Other Spirochetal and Tick-Borne Disorders, New York, NY, 1999.
Suggested Readings
- Oliver Jr JH, Kollars Jr TM, Chandler Jr FW, et al: First Isolation and Cultivation of Borrelia burgdorferi Sensu Lato from Missouri. J Clin Micro 36:1-5,1998.
- Masters E, Granter S, Duray P, et al: Physician-Diagnosed Erythema Migrans and Erythema Migrans-like Rashes Following Lone Star Tick Bites. Arch Dermatol 134:955-960, 1998.
Lyme Disease in Dogs: Basic Research
Reinhard K. Straubinger (DVM, DrMedVet, PhD)
This presentation focused on two major topics: the quantification of Borrelia burgdorferi-specific DNA in canine tissue, and the efficacy of antibiotic treatment in dogs infected with the spirochete demonstrated by means of quantified DNA in canine tissue.
DNA fragments of specific interest can be amplified with a commonly used technique called polymerase chain reaction (PCR). Double-stranded DNA is separated or denatured by heat (94ºC). Short pieces of DNA, called primers and designed by the researcher to bind to specific sites on the sense and anti-sense strands of the DNA, bind to the single strands of the target DNA at a temperature normally below 72ºC. Finally, these short pieces of newly created double-stranded DNA are recognized by the Taq polymerase, an enzyme that optimally extends DNA in one direction at exactly 72ºC. Repeating this cycle -- denaturation, annealing, extension -- up to 40 times results in an exponential amplification of the desired DNA fragment. Subsequently, DNA is separated on agarose gels according to its size and visualized.
This technique is a perfect tool to use when small amounts of DNA are present in a sample and the researcher is only interested in the presence or absence of this particular DNA. However, quantification of DNA is very difficult and time consuming when this is the only method available. In an attempt to address this issue, Applied Biosystems recently introduced the ABI 7700 Sequence Detection System (Fig. 1).[1] This tool measures DNA during amplification using a probe (short piece of DNA) labeled with two fluorescent dyes. As long as both dyes, the reporter and the quencher dye, are attached to the probe, no signal is emitted.

Figure 1
Similar to the primers, the probe is designed to bind to the DNA fragment of interest, but it will bind to a sequence flanked by both primers. During amplification, the Taq polymerase will recognize the probe and, due to its exonuclease activity, start to cleave the probe. Once the reporter and quencher dyes are separated, free reporter dye is excited with laser light, and the reflected signal is detected with a camera. The reporter dye accumulates in the reaction solution during each single successful amplification of the specific DNA fragment and the amount of reflected signal is then correlated to the amount of DNA.
This new technique has been used to measure the effectiveness of antibiotic treatment in infected dogs (Fig. 2).[2] The study involved four dogs that had been infected with Borrelia burgdorferi by tick bites and 12 dogs that had been infected but received antibiotic therapy (azithromycin, doxycycline, or ceftriaxone) 120 days after tick exposure. Skin biopsy tissues and tissues from all of the study animals were subjected to quantitative PCR testing. Shortly after infection, the number of spirochetes was about 1 million to 10 million in tissue samples that yielded 100 µg of DNA.

Figure 2
In untreated dogs, the number of organisms declined during the 300 days following infection to undetectable levels in skin punch biopsy samples (Fig. 3). But the spirochetes did not disappear. More than 500 days after infection, spirochete DNA was found in skin and deeper tissue, but the number of detected organisms was 100- to 1,000-fold less than during the early stage of infection (Fig. 4).

Figure 3

Figure 4
Similarly, the antibiotic-treated dogs had high numbers of B burgdorferi organisms in skin punch biopsy samples during the first 120 days. after infection. During treatment and shortly thereafter, spirochetes were not detectable. Later, however, a few skin punch biopsies became positive again (Fig. 5). Similarly, a few tissue samples taken from deeper sites were positive more than 350 days after antibiotic treatment had ended (Fig. 6).

Figure 5

Figure 6
An interesting question is whether the detected B burgdorferi-specific DNA could be attributed to live spirochetes. A recent study described that DNA of heat-killed treponema organisms injected into animals disappeared quickly after the injection.[3] These studies confirm earlier study results.[4]
References
- Desjardin LE, Chen Y, Perkins MD, et al: Comparison of the ABI 7700 System (TaqMan) and competitive PCR for quantification of IS 6110 DNA in sputum during treatment of tuberculosis. J Clin Microbiol 36:1964-1968, 1998.
- Straubinger RK: Quantitative spirochetal DNA in dog tissue. 12th International Conference on Lyme Disease and Other Spirochetal and Tick-Borne Disorders, New York, NY, 1999.
- Wicher K, Abbruscato F, Wicher V, et al: Identification of persistent infection in experimental syphilis by PCR. Infect Immun. 66:2509-2513, 1998.
- Straubinger RK, Summers BA, Chang Y-F, et al: Persistence of Borrelia burgdorferi in experimentally infected dogs after antibiotic treatment. J Clin Microbiol 35:111-116.
Borreliacidal Antibodies Against OspC: Implications for Vaccine Development and Serodiagnosis
Charles S. Pavia, PhD
The final presentation delivered at Friday's session dealing with vaccines was given by Dr. Steven Callister, who covered the production of borreliacidal antibody in patients with early Lyme disease. He emphasized the role of outer surface protein C (OspC) for diagnostic puprposes and as a possible future vaccine candidate.
Dr. Callister, affiliated with the Gunderson Lutheran Medical Center in La Crosse, Wis., is widely regarded as an expert in diagnostic testing procedures for Lyme disease with special emphasis on the borreliacidal antibody test.
Dr. Callister reviewed the kinetics and nature of the two major types of antibodies (also known as immunoglobulins) that are commonly produced as part of the host response during infections, such as those attributable to Borrelia burgdorferi. Of particular interest is the role these antibodies play in early stage Lyme disease.
These antibodies belong to two major isotypes -- IgM and IgG -- and usually appear in the infected host in a predictable sequence. IgM is produced first, usually during the first 2 to 3 weeks after initial exposure to Borrelia bacteria. Following IgM production, a switch occurs, leading to the formation of IgG. As IgM begins to wane, increasing amounts of IgG are produced. Production continues for the duration of an untreated infection.
Functionally, these antibodies can be considered as either opsonizing or as borreliacidal. Opsonins attach themselves to a particular antigen(s) of a pathogen, allowing it to be better recognized and subsequently engulfed by a phagocytic cell such as a macrophage. Borreliacidal antibodies also attach themselves to the outer surface of the pathogen and, often in the presence of complement, will directly kill the organism.
Associated with Borrelia death caused by these antibodies is the appearance of "blebs" - round, compact pieces of borrelial protein formed on the pathogen's surface. These highly specific antibodies are produced in response to stimulation of the human immune system by B burgdorferi outer surface proteins (Osp), such as OspA, OspB, OspC and possibly several others. Borreliacidal antibodies are a highly specific indication of spirochetal infection.
Careful serologic analyses conducted by Dr. Callister revealed that OspC and certain other borrelial proteins are capable of inducing the production of borreliacidal antibodies shortly after natural infection. Borreliacidal antibodies directed against OspA and OspB are produced primarily during the latter stages of untreated Lyme disease.
A somewhat perplexing aspect of this work is that, despite the formation of high concentrations of borreliacidal antibodies at various stages of Borrelia infection, Lyme disease spirochetes are not completely eliminated.
Implications for Vaccine Development
Dr. Callister pointed out that the detection of anti-OspC, rather than other Osp, has implications for vaccine development and serodiagnosis. Vaccinating hamsters with purified preparations of OspC confers protection to a subsequent challenge inoculum - infection is prevented and the protected animals are free of any significant disease manifestations.
Dr. Callister believes that high levels of anti-Osp C antibodies resulting from vaccinating the hamsters are responsible for affording protection. These findings are similar to what occurs in other animal models, such the mouse, where it has been known for nearly a decade that vaccination with OspA protects mice from a subsequent challenge infection with B burgdorferi.
Using a highly specialized detection system involving flow cytometry, Dr. Callister showed that a significant number of patients with early Lyme disease produce borreliacidal antibodies reactive with OspC. It is especially important to realize that Borrelia strains such as 297 express little or no OspC, compared with strains such as 50772. Interestingly, Strain 50772 lacks OspA and OspB. Accordingly, to detect OspC antibodies, the appropriate Borrelia strain must be used.
In a recent collaborative effort between the Centers for Disease Control and Dr. Callister's laboratory, blinded serum samples (provided by the CDC) were analyzed for the presence of borreliacidal antibodies. High levels of borreliacidal antibodies were detectable in 70% of culture-positive patient sera using the OspA/B deficient strain 50772 expressing OspC. Antibody titers were reduced significantly following absorption with purified OspC.
These data correlated well with the CDC's ELISA results for these same serum samples. These same antisera had little or no borreliacidal activity against strain 297. Sera from patients with other infectious (including syphilis) or non-infectious disorders were non-reactive.
A Better Vaccine Candidate?
Dr. Callister finished his presentation by indicating that, besides OspA, it would be worthwhile to consider OspC as a vaccine candidate for the prevention of Lyme disease, especially because it seems to be highly immunogenic in both humans and hamsters.
OspC might be better than OspA since its effectiveness would not rely solely on Borrelia neutralization within the tick, as it feeds on a human host. Because of its high degree of sensitivity and specificity, coupled with its detection of OspC antibodies, the borreliacidal antibody test should be considered for further use a diagnostic tool in the detection of earely stage Lyme disease
Reference
- Callister SM: Borreliacidal antibodies against OspC: Implications for vaccine development and serodiagnosis. 12th International Conference on Lyme Disease and Other Spirochetal and Tick-Borne Disorders, New York, NY, 1999.
Suggested Readings
- Callister SM, Jobe DA, Schell RF et al: Sensitivity and specificity of the borreliacidal antibody test during early Lyme disease: a gold standard. Clin Diag Lab Immunol 3:399-402, 1996.
- Pavia CS, Wormser GP & Norman GL: Activity of sera from patients with Lyme disease against Borrelia burgdorferi. Clin Infect Dis 25(Suppl 1):S25-30, 1997.
Register For CME Credit
This information is needed for granting continuing education credits and mailings regarding this website only. To receive CME credits, or information concerning future courses, you must fill-in all fields.
If you give us your e-mail address, we can e-mail you notices about future programs.
All material on this website is protected by copyright. Copyright © 1994-1999 by Medscape Inc. All rights reserved. This website also contains material copyrighted by 3rd parties. CME means Continuing Medical Education credit is available. Medscape requires 3.x browsers or better from Netscape or Microsoft.
Version: 22Jan. 2004
URL
Home
Joachim Gruber





